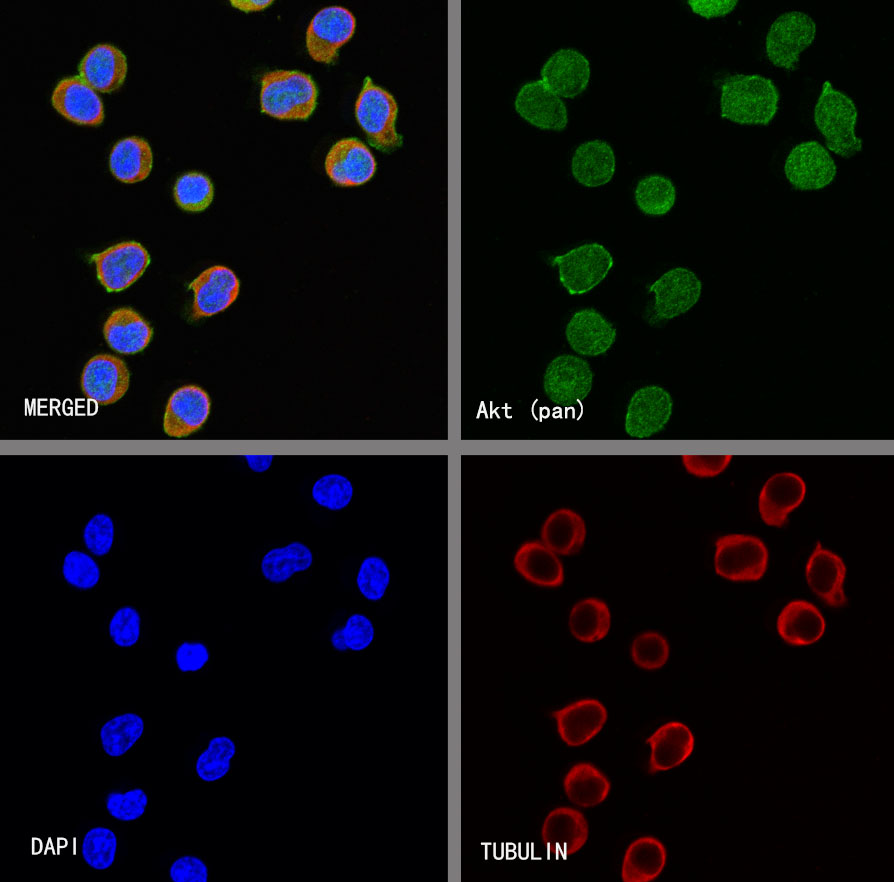

WB result of Akt (pan) Rabbit mAb
Primary antibody: Akt (pan) Rabbit mAb at 1/1000 dilution
Lane 1: GST-Akt1 protein 10 ng
Lane 2: GST-Akt2 protein 10 ng
Lane 3: GST-Akt3 protein 10 ng
Secondary antibody: Goat Anti-rabbit IgG, (H+L), HRP conjugated at 1/10000 dilution
Predicted MW: 72 kDa
Observed MW: 60~100 kDa
Product Details
Product Details
Product Specification
| Host | Rabbit |
| Immunogen | Recombinant Protein |
| Location | Cytoplasm, Nucleus, Cell membrane |
| Accession | P31749、 Q9Y243、 P31751 |
| Clone Number | S-652-20 |
| Antibody Type | Recombinant mAb |
| Isotype | IgG |
| Application | WB, IHC-P, ICC, IP, ICFCM |
| Reactivity | Hu, Ms, Rt |
| Purification | Protein A |
| Concentration | 0.5 mg/ml |
| Conjugation | Unconjugated |
| Physical Appearance | Liquid |
| Storage Buffer | PBS, 40% Glycerol, 0.05% BSA, 0.03% Proclin 300 |
| Stability & Storage | 12 months from date of receipt / reconstitution, -20 °C as supplied |
Dilution
| application | dilution | species |
| WB | 1:1000 | |
| IHC-P | 1:250 | |
| ICFCM | 1:500 | |
| ICC | 1:500 | |
| IP | 1:50 |
Background
AKT protein, also known as protein kinase B (PKB) or RAC-PK, is a key molecule in cellular signaling pathways that belongs to the serine/threonine protein kinase family. AKT protein exerts extensive biological effects by phosphorylating downstream target proteins, including mTOR, GSK3β, FoxO, and others. These targets are involved in various biological processes, such as cell growth, proliferation, differentiation, and apoptosis. However, abnormal activation of AKT protein is closely related to the development of multiple diseases, including cancer, diabetes, and neurodegenerative diseases.
Picture
Picture
Western Blot
WB result of Akt (pan) Rabbit mAb
Primary antibody: Akt (pan) Rabbit mAb at 1/1000 dilution
Lane 1: Jurkat whole cell lysate 20 µg
Lane 2: MCF7 whole cell lysate 20 µg
Lane 3: HeLa whole cell lysate 20 µg
Lane 4: A549 whole cell lysate 20 µg
Lane 5: NIH/3T3 whole cell lysate 20 µg
Lane 6: C2C12 whole cell lysate 20 µg
Lane 7: C6 whole cell lysate 20 µg
Secondary antibody: Goat Anti-rabbit IgG, (H+L), HRP conjugated at 1/10000 dilution
Predicted MW: 56 kDa
Observed MW: 60 kDa
FC

Flow cytometric analysis of 4% PFA fixed 90% methanol permeabilized Jurkat (Human T cell leukemia T lymphocyte) labelling Akt (pan) antibody at 1/500 dilution (0.1 μg)/ (Red) compared with a Rabbit monoclonal IgG (Black) isotype control and an unlabelled control (cells without incubation with primary antibody and secondary antibody) (Blue). Goat Anti - Rabbit IgG Alexa Fluor® 488 was used as the secondary antibody.
IP

Akt (pan) Rabbit mAb at 1/50 dilution (1 µg) immunoprecipitating Akt (pan) in 0.4 mg Jurkat whole cell lysate.
Western blot was performed on the immunoprecipitate using Akt (pan) Rabbit mAb at 1/1000 dilution.
Secondary antibody (HRP) for IP was used at 1/1000 dilution.
Lane 1: Jurkat whole cell lysate 20 µg (Input)
Lane 2: Akt (pan) Rabbit mAb IP in Jurkat whole cell lysate
Lane 3: Rabbit monoclonal IgG IP in Jurkat whole cell lysate
Predicted MW: 56 kDa
Observed MW: 60 kDa
Immunohistochemistry
IHC shows positive staining in paraffin-embedded human breast cancer. Anti-Akt (Pan) antibody was used at 1/250 dilution, followed by a HRP Polymer for Mouse & Rabbit IgG (ready to use). Counterstained with hematoxylin. Heat mediated antigen retrieval with Tris/EDTA buffer pH9.0 was performed before commencing with IHC staining protocol.
IHC shows positive staining in paraffin-embedded human ovarian cancer. Anti-Akt (Pan) antibody was used at 1/250 dilution, followed by a HRP Polymer for Mouse & Rabbit IgG (ready to use). Counterstained with hematoxylin. Heat mediated antigen retrieval with Tris/EDTA buffer pH9.0 was performed before commencing with IHC staining protocol.
IHC shows positive staining in paraffin-embedded human thyroid cancer. Anti-Akt (Pan) antibody was used at 1/250 dilution, followed by a HRP Polymer for Mouse & Rabbit IgG (ready to use). Counterstained with hematoxylin. Heat mediated antigen retrieval with Tris/EDTA buffer pH9.0 was performed before commencing with IHC staining protocol.
Immunocytochemistry
ICC shows positive staining in Jurkat cells. Anti-Akt (pan) antibody was used at 1/500 dilution (Green) and incubated overnight at 4°C. Goat polyclonal Antibody to Rabbit IgG - H&L (Alexa Fluor® 488) was used as secondary antibody at 1/1000 dilution. The cells were fixed with 4% PFA and permeabilized with 0.1% PBS-Triton X-100. Nuclei were counterstained with DAPI (Blue).Counterstain with tubulin (red).
